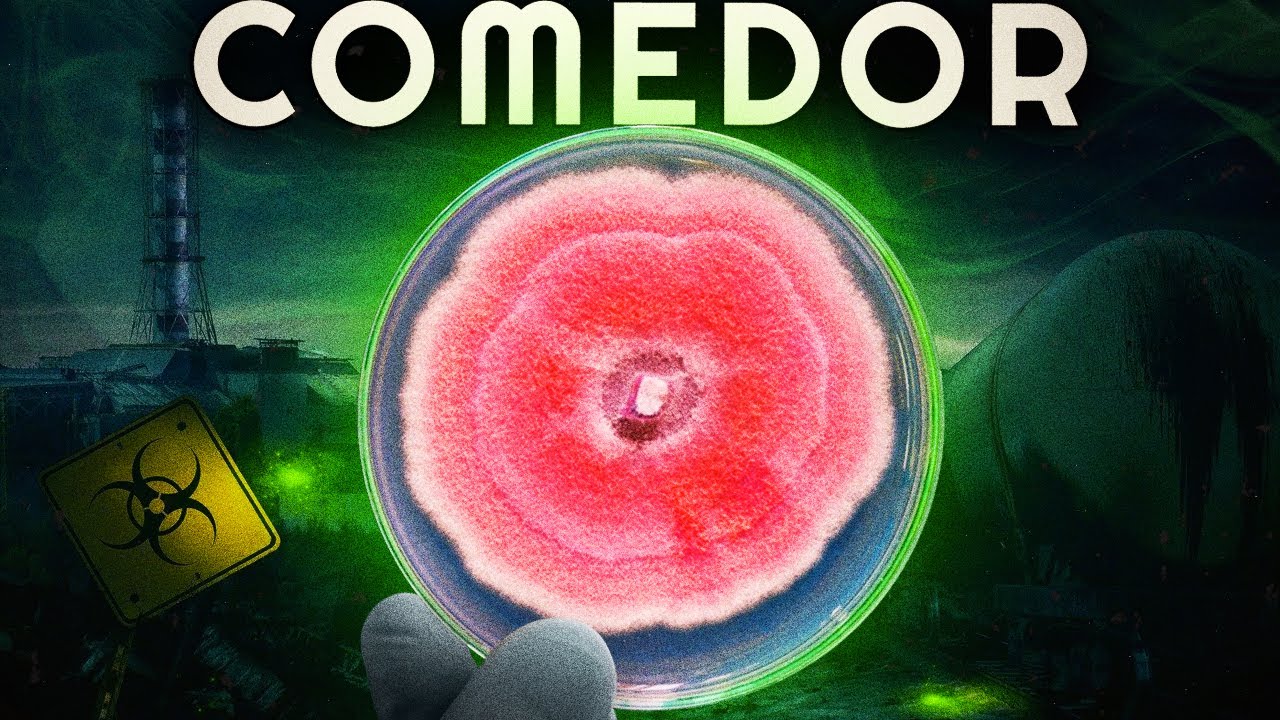
como FUNGOS COMEM a RADIAÇÃO de CHERNOBYL?

Você pode pensar que nasceu na cidade errada quando lembra que sua banda favorita nunca vai tocar por aí. Você pode pensar até que nasceu no país errado quando pensa como faz calor ou frio demais. Mas eu tenho uma notícia ainda mais desanimadora, você nasceu no planeta errado!
Errado, não porque você não gosta dele, mas porque ele não é o ideal pra você… pelo menos não biologicamente. De certa forma, a biologia, o estudo da vida, é uma das ciências mais tristes que existem. Nós só temos uma amostra de vida: A vida no planeta Terra.
É por essa infelicidade que a busca por vida fora da Terra é tão importante. Finalmente biólogos teriam alguma outra coisa para estudar além de seres terrestres. E sim, descobrir vida fora da terra responderia algumas perguntas existenciais, isso teria o potencial de mudar a ciência, filosofia, religiões mas… deixar biólogos felizes é mais importante.
Certo, então, como buscamos vida fora da Terra? Basicamente nós usamos a Terra como referência de planeta com vida, e a partir daí buscamos planetas parecidos. Essa é uma ideia conhecida como: Princípio da Mediocridade.
E sim, esse princípio afirma que eu sou medíocre, mas não de um jeito ruim. Algo medíocre é algo comum, e o princípio da mediocridade afirma que as condições para vida presentes no nosso planeta devem estar presentes em inúmeros planetas na nossa galáxia. Em resumo… nós não somos especiais.
Esse é o princípio que guia a busca por vida fora na Terra: queremos planetas parecidos com a Terra. E como a vida na Terra é composta de químicos a base de carbono diluídos em água, planetas candidatos à vida são planetas que podem ter água líquida e composição química parecida. Além disso, outros fatores também são bem importantes.
Por exemplo, se o Sol fosse mais quente, ou se a Terra estivesse mais perto do Sol, nosso planeta não teria água líquida e a vida seria impossível. Inclusive a vida no planeta Terra tem uma data de validade, o Sol está ficando mais quente conforme envelhece. Em pouco mais de um bilhão de anos ele vai ser quente demais para a vida na terra e a terra não vai mais ser um bom planeta para vida.
Esse vai se tornar o grande evento de extinção em massa, o último e derradeiro, que diferentemente dos outros cinco que já aconteceram na história da terra, desta vez não vai sobrar nada além de um mundo completamente estéril. Então o nosso planeta possui suas limitações pra vida. E nada nos impede de um dia encontrar um outro lugar com limitações menores.
Quem sabe não possamos encontrar um planeta ainda mais habitável do que a terra. Um planeta super habitável. Planetas nos quais a vida não só é possível surgir, mas no qual a vida vai poder alcançar a biodiversidade máxima.
Onde os ecossistemas vão poder se expandir e preencher cada milímetro quadrado com vida. Por isso, ao invés de procurar outros mundos como a Terra, talvez faça mais sentido se perguntar: Qual exatamente é a cara de um planeta ideal para vida? Um planeta que maximize o seu potencial para vida precisa maximizar o tempo disponível para vida surgir e evoluir.
A evolução de vida complexa na Terra demorou bilhões de anos, e em só um bilhão de anos essa vida complexa não vai mais existir devido ao aquecimento natural do Sol… é, isso é triste! Um planeta super habitável não teria um problema desses, e seria bem mais amigável à vida durante toda sua história. Isso significa que um planeta super habitável deve orbitar sua estrela a uma distância grande o suficiente para a evolução dela não destruir tão cedo sua capacidade de abrigar vida, diferente da Terra.
Além disso, estrelas Amarelas como o Sol não são ideias para vida, um lugar muito melhor seriam estrelas um pouco menores como Anãs Laranjas. Anãs Laranjas são quentes o suficiente para água líquida e grandes quantidades de energia solar para plantas alienígenas, mas também duram muito mais tempo que o sol. Algumas anãs laranjas têm vidas até dez vezes mais longas que o sol, o que é muito tempo para a vida surgir, evoluir e se diversificar bastante.
Outra vantagem de Anãs laranjas é que elas emitem muito menos radiação ultravioleta do que estrelas como o Sol. E a radiação UV pode atrapalhar o surgimento de vida quebrando químicos como DNA. Então sabemos onde o planeta ideal deve estar: A uma distância moderada de uma estrela Anã Laranja… Mas como o planeta em si deve ser?
O tamanho ideal para um planeta super habitável é de aproximadamente dezesseis mil quilômetros de diâmetro, o que é trinta por cento maior que o nosso planeta, e com duas vezes a massa da Terra. Esse é o tamanho ideal para maximizar a chances da existência de placas tectônicas e atividade vulcânica, que é útil para existência de gases estufa. E gases estufas são importantes para o planeta conseguir manter uma temperatura equilibrada adequada a água líquida.
Além disso, um planeta maior significa que a atmosfera do planeta vai ser mais densa do que a nossa devido à gravidade adicional, e vai existir uma área maior na superfície no planeta Com mais área tem mais lugares para vida surgir e ocupar, e com mais atmosfera tem mais material para vida usar. Ou seja, até aqui a Terra não tem nada de especial, inclusive ela não tem nenhum dos fatores ideais para vida… mas ela tem! Um planeta super habitável precisa ser como a Terra no sentido de que não pode ter dias excessivamente longos, como vênus em que os dias tem mais de cinco mil e oitocentas horas!
Dias tão longos assim tornaram água líquida impossível. Além disso, assim como a Terra, é bom que esse planeta super habitável conte com a presença de uma lua relativamente grande, pois é útil para proteger ele de impactos de asteroides. Outro fator importante é a presença de um campo magnético planetário, uma magnetosfera, que protege a superfície de radiação vinda do espaço.
E esses são os únicos três fatores do planeta perfeito que a Terra tem. Ou seja, a Terra talvez não seja um planeta tão bom assim para vida, talvez a Terra não seja medíocre como pensávamos, talvez seja PIOR DO QUE MEDÍOCRE. É, você nasceu no planeta errado, com o tamanho errado pra vida, orbitando uma estrela quente demais e perto demais.
Vida na Terra talvez seja especial não porque a vida é incomum no universo, mas porque vida em planetas desagradáveis como a Terra seja uma raridade. Talvez ser como a Terra não seja um bom critério para um lugar ideal pra vida. E se esse for o caso, precisamos mudar nosso foco de busca de vida extraterrestre.
Precisamos então focar em mundos diferentes do nosso, precisamos olhar os planetas super habitáveis… E isso é uma ÓTIMA notícia. Na via láctea as estrelas ideais para vida, as Anãs Laranjas, são bem mais comuns do que estrelas amarelas como Sol, representando doze por cento da nossa galáxia, enquanto as estrelas como o Sol são só oito por cento. Além disso, a maior parte dos planetas rochosos como a Terra encontrados fora do sistema solar são um pouco maiores que o nosso mundo.
Isso pelo menos indica que planetas no tamanho ideal são comuns no universo. Dos mais de quatro mil candidatos a planetas fora do sistema solar, vinte e quatro deles são bons candidatos a planetas super habitáveis. E quem sabe um deles possa nos supreender!
A biodiversidade em tais planetas seria incompreensível, cada canto desses mundos super habitáveis abrigando novas formas de vida, cada uma mais surpreendente do que a outra. Ecossistemas que são praticamente inimagináveis à nossa mente terrestre podem se espalhar através desses mundos super habitáveis. A biodiversidade em tais lugares seria estonteante, tornando a Terra, com toda a sua glória e beleza, apenas uma pequena gota no vasto oceano da vida.
E quem pode dizer que um dia, quando a Terra finalmente se tornar muito quente para abrigar a vida, a humanidade não poderá chamar um desses planetas super habitáveis de lar? E indo ainda mais longe, se esta não for apenas uma possibilidade, mas uma necessidade? A transição da humanidade para um planeta super habitável poderia ser a próxima etapa da nossa evolução.
Não como um ato de escapismo ou de abandono do nosso lar natal, mas como uma expansão, um crescimento, uma celebração do poder da vida para se adaptar e prosperar em lugares incríveis e desconhecidos. Portanto, não se deixe desanimar pela mediocridade terrestre, pela possibilidade de que tenhamos nascido no planeta 'errado'. Em vez disso, deixe sua mente se abrir para o futuro que está por vir.
Nas profundezas do espaço, há mundos esperando por nós, cheios de belezas e mistérios que superam tudo o que conhecemos. Então, olhe para as estrelas com esperança, com curiosidade e com uma sensação de maravilha. Nós estamos apenas começando nossa jornada, não importa se de um planeta certo ou errado.
E não é errado dizer que existem alces no fundo do mar! Agora pra saber porque existe tantos alces no fundo do mar basta clicar bem aqui no maior canal de ciência do nordeste, e tchau!